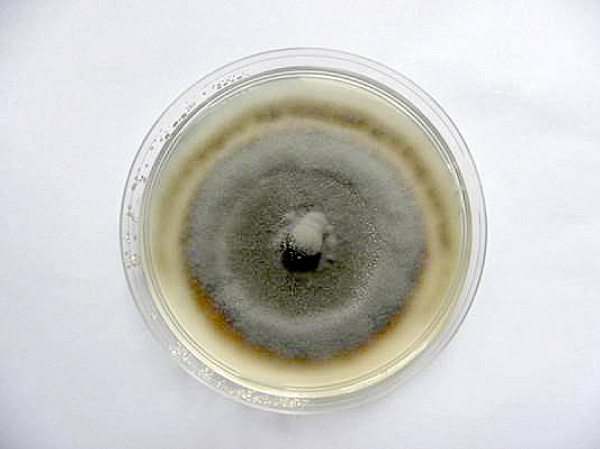
Obr. 2: Kontrola - kultura Oculimacula sp. na bramboro-dextr&oacute;zov&eacute;m agaru (PDA) po 4 t&yacute;dnech kultivace (18 &deg;C, tma)

Studium původců stéblolamu v ČR a jejich rezistence vůči fungicidům
29. 04. 2017 Choroby Zobrazeno 1594x
Stéblolam je závažná choroba obilnin, která je ve světě i v našich podmínkách stále aktuálním problémem. Důvodů je celá řada včetně zavádění bezorebných technologií, nedostatků ve zpracování půdy a zejména zkrácení osevních postupů bez víceletých pícnin, kdy jsou často pěstovány obilniny po obilnině. Mnohé fungicidy ztrácejí svou účinnost vlivem narůstající míry rezistence původců onemocnění. Je třeba hledat nové způsoby ochrany na bázi odolnosti odrůd.
Původcem stéblolamu jsou dva druhy rodu Oculimacula (O. yallundae, O. acuformis, dříve Pseudocercosporella herpotrichoides var. herpotrichoides a acuformis). Hostitelský okruh obou druhů je široký, zahrnuje pšenici, ječmen, oves, žito, tritikale, rýži a plané druhy trav.
Původci a životní cyklus
Oculimacula yallundae (OY) a Oculimacula acuformis (OA) se navzájem liší morfologicky, rychlostí růstu, virulencí k jednotlivým hostitelům a citlivostí k účinným látkám fungicidů. Většinou se vyskytují současně na jednom poli, dokonce i na jednom stéble, a mají pravděpodobně stejný životní cyklus.
Hlavní formou inokula na poli jsou konidie produkované na infikované slámě na podzim a v předjaří. Tyto spory se šíří deštěm na krátké vzdálenosti a mohou kontaminovat pšenici od podzimu do jara. Po infekci koleoptile proniká patogen vrstvami listové pochvy až ke stéblu.
První příznaky ve formě hnědých protáhlých skvrn těsně nad povrchem půdy se objevují koncem odnožování až počátkem sloupkování. V této fázi však nelze pouhým okem odlišit pravý stéblolam od jiných chorob pat stébel. Typické podlouhlé skvrny ve tvaru oka s tmavými sklerociálními buňkami uprostřed (obr. 1) se objevují až v pozdějších fázích sloupkování a metání. Uvnitř stébla je patrné šedavé vatovité mycelium a stéblo se v místě skvrn láme. OY a OA se liší v rychlosti rozvoje infekce, OY se většinou uchytí na stéble pšenice rychleji než OA. Nicméně výsledný stupeň infekce v době zrání je obdobný u obou druhů. Napadené rostliny koncem vegetace předčasně zasychají, tzv. běloklasost je typickým projevem infekce všemi původci chorob pat stébel.
Stéblolam je často považován za monocyklické onemocnění. Výskyt sekundárních infekcí v porostu v průběhu sezony, jako je tomu u většiny houbových patogenů obilnin, není u stéblolamu pravděpodobný. Askospory (pohlavní spory) vznikají pouze tehdy, dojde-li ke splynutí mycelia odlišných párovacích typů MAT1-1 a MAT1-2. Askospory se mohou šířit větrem na dlouhé vzdálenosti, nepředstavují však hlavní zdroj inokula. Nicméně sexuální reprodukce vede k vyšší genetické variabilitě v populaci patogena, která pak může lépe reagovat na selekční tlaky způsobené např. užíváním fungicidů.

Obr. 1: Stéblolam na odrůdě Cubus
Ochrana
Vhodný osevní postup, pozdější termín setí, odolné odrůdy, včasná detekce patogenu a chemická ochrana počátkem sloupkování (do fáze 2. kolénka!). Druhé fungicidní ošetření se provádí v případě příznivých podmínek pro rozvoj stéblolamu, a to koncem metání. Účinné látky doporučené proti stéblolamu jsou např. boscalid, prothioconazole, epoxiconazole, cyprodinil, metrafenone.
Ve světě byla popsána rezistence vůči účinným látkám, jako jsou benzimidazoly nebo prochloraz, proto by měla být studiu úrovně rezistence českých populací věnována mimořádná pozornost (viz dále).
Odolnost odrůd
V literatuře jsou popsány tři geny rezistence vůči stéblolamu Pch1, Pch2, Pch3 (Pch = Pseudocercosporella herpotrichoides). Gen Pch1, odvozený od mnohoštětu Aegilops ventricosa, je z nich nejúčinnější. Do pšenice byl gen Pch1 přenesen již v šedesátých letech minulého století a odolnost, kterou řídí, je zvyšována dalšími geny malého účinku. Jeho nositelem jsou z odrůd pěstovaných u nás např. Hermann, Annie, Manager, Princeps, Rebell. Odrůda Hermann vykazovala nejvyšší úroveň rezistence vůči stéblolamu z testovaných odrůd ozimé pšenice v polních podmínkách i v maloparcelovém infekčním pokusu. Obecně bylo u odrůd nesoucích gen Pch1 zaznamenáno statisticky průkazně nižší napadení komplexem chorob pat stébel než u odrůd bez tohoto genu.
Další gen rezistence vůči stéblolamu Pch2 byl nalezen v genomu staré francouzské odrůdy Cappelle-Desprez a jeho účinnost byla známá již před využíváním genu Pch1. Při silném výskytu stéblolamu však neposkytuje dostatečnou ochranu, což do určité míry platí i pro gen Pch1. Účinnost genů Pch1 a Pch2 k jednotlivým původcům je odlišná. Pch1 má vyšší účinnost k OY, Pch2 pak k OA. Je tedy důležité, jaký druh v populaci právě převažuje. Odrůda Cappelle-Desprez byla v minulosti hojně využívána ve šlechtění pšenice, proto lze předpokládat přítomnost genu Pch2 v evropských odrůdách. V literatuře se uvádí zvýšení odolnosti odrůdy u kombinace Pch1 a Pch2. Tuto kombinaci má např. odrůda Rendezvous a Lynx. U našich odrůd o přítomnosti genu Pch2 zatím nevíme, odrůd s Pch2 je i v literatuře poměrně málo. Pokud by se nějaká odrůda nesoucí Pch2 u nás vyskytla, musela by mít v rodokmenu např. Capelle-Desprez, Lynx, Rendezvous nebo Riband. Rendezvous mají v rodokmenu např. odrůdy Torfrida, Balthazar, Beaufort, Hussar, Corsaire.
Rezistence vůči fungicidům
Rezistence vůči pesticidům je obecně velkým celosvětovým problémem. Rezistentní populace proti různým účinným látkám jsou popsány nejen u škůdců, ale i u houbových původců chorob zemědělsky významných plodin. Konkrétně u stéblolamu je systém chemické ochrany dokonale propracován např. ve Francii a Velké Británii. Tomu ale předcházely rozsáhlé studie populací patogenu, zastoupení jednotlivých druhů (OY a OA) a jejich citlivost k účinným látkám používaných fungicidů v různých oblastech daného státu. Ve Francii např. v roce 1980 převažovala OY, v letech 1985–1995 byl zaznamenán nárůst OA a v r.oce1998 opět převažovala OY.
Počátky chemické ochrany proti stéblolamu spadají do 70. let minulého století se zavedením benzimidazolových fungicidů (např. carbendazim). Již o 10 let později byla zjištěna rezistence některých kmenů OY i OA vůči těmto účinným látkám a do popředí se dostaly přípravky na bázi inhibitorů syntézy sterolů (DMI) - triazoly (např. bromuconazole, cyproconazole, epoxiconazole), prochloraz a prothioconazole (od roku 2006). Ve Francii byla v 90. letech potvrzena rezistence vůči triazolům a prochlorazu u obou původců stéblolamu a zároveň byl registrován cyprodinil. V roce 2006 byly do ochrany proti stéblolamu zavedeny dvě nové účinné látky: boscalid a metrafenone. U cyprodinilu byla popsána rezistence pouze ojediněle, u boscalidu v kombinaci s prothioconazolem jen výjimečně u kmenů OY.
Situace u nás
V našich podmínkách se takto rozsáhlému studiu populací původců stéblolamu nikdo nevěnoval. Nevíme tudíž, jaký druh u nás převažuje ani jaká je citlivost jednotlivých kmenů rodu Oculimacula k účinným látkám. V dílčí sbírce kultur VÚRV, v.v.i. je od roku 2013 uloženo 130 izolátů r. Oculimacula pocházejících z ČR, které jsou postupně druhově determinovány pomocí molekulárních markerů a testovány na rezistenci vůči fungicidům metodou sterilních terčíků (viz obr. 3).
Z předběžných výsledků se zdá, že v ČR převažuje OY a poměrně často se vyskytují oba druhy zároveň na jednom stéble. Pro fungicidní testy in vitro byly použity přípravky Bumper (prochloraz + propiconazole), Prosaro (prothioconazole + tebuconazole) a Efilor (boscalid + metconazole). Nejvyšší redukce růstu patogenu vzhledem k neošetřené kontrole byla zaznamenána u kombinace prochloraz + propiconazole, na druhém místě byla kombinace boscalid + metconazole a prothioconazole + tebuconazole vykazovaly nejnižší účinnost (obr. 2, 3). Toto platilo pro většinu z 52 testovaných izolátů rodu Oculimacula pocházejících z okresů Praha-východ, Pelhřimov a Rakovník. Na základě statistického vyhodnocení je však zřejmé, že reakce jednotlivých izolátů k testovaným fungicidům je specifická. Např. jeden z izolátů OA z Pelhřimova vykazoval pouze cca 60% redukci růstu oproti kontrole při aplikaci kombinace prochloraz + propiconazole.
Obr. 2: Kontrola - kultura Oculimacula sp. na bramboro-dextrózovém agaru (PDA) po 4 týdnech kultivace (18 °C, tma)

Obr. 3: a) Bumper, b) Efilor, c) Prosaro - horní sterilní terčík ponořen do fungicidu, spodní do sterilní vody - kultura Oculimacula sp. na PDA po 4 týdnech kultivace (18 °C, tma)
Závěr
Dlouhé teplé podzimní měsíce posledních let a výše zmíněné agrotechnické nedostatky napomáhají zvýšené produkci inokula stéblolamu na posklizňových zbytcích. Ani včasné ošetření ve fázi BBCH 31–32 nemusí být vždy zárukou úspěšného potlačení stéblolamu, který může způsobit až 50% ztráty na výnosech.
Většina testovaných kmenů rodu Oculimacula nevykazovala rezistenci vůči prochlorazu, jak je tomu např. ve Francii. Do budoucna by bylo třeba provádět každoroční plošný průzkum původců stéblolamu, abychom měli stále aktuální informace o výskytu rezistentních kmenů rodu Oculimacula na našem území.
Seznam literatury je k dispozici u autorů článku.
Příspěvek vznikl za podpory MZe ČR projektu NAZV QJ1530373 a institucionálního příspěvku MZe RO0416.
Mgr. Jana Palicová, Ph.D., Mgr. Alena Hanzalová, Ph.D., RNDr. Veronika Dumalasová, Ph.D., Ing. Pavel Bartoš, DrSc.; Výzkumný ústav rostlinné výroby, v.v.i., Praha-Ruzyně
foto: J. Palicová
Další články v kategorii Choroby














RSS
RSS